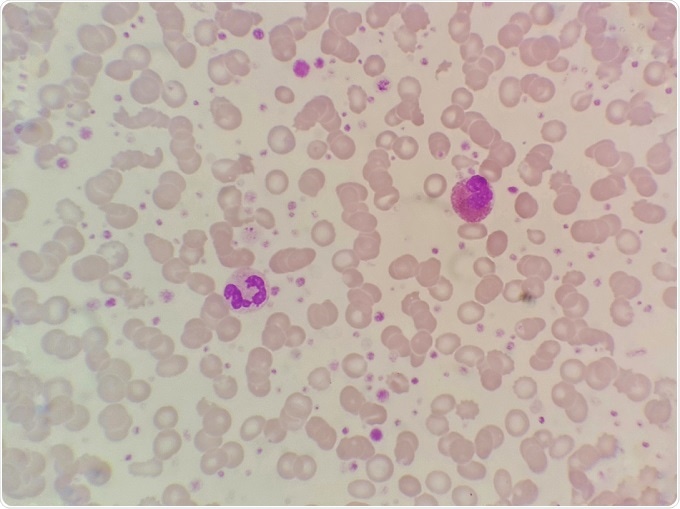

Blood biomarkers that predict accelerated loss of lung function have been identified in a study of fire-fighters who worked in the aftermath of the World Trade Center disaster.
After the collapse of the World Trade Center on September 11 2001 rescue and recovery workers, including the Fire Department of the City of New York, spent long hours working at the scene. The vast dust cloud ensuing from the disaster contained large-sized particulate matter, caustic dust and products of combustion.
As a consequence of inhaling such contaminated air, many of the New York City fire department rescue and recovery workers presented with lung injury and loss of lung function. A great disparity in the evolution of symptoms was observed among those affected. Although the decline in lung function stabilised in the majority of cases, there were some individuals who experienced continued decline and some whose lung function improved.
It was discovered that many of the individuals experiencing rapid decline in lung function had higher levels of eosinophils. These cells form part of the body's immune system and are commonly implicated in respiratory disease. Further analyses were thus conducted to assess whether there was a correlation between the concentration of white blood cells and excessive loss of lung function after lung damage.
Blood smear sample showing eosinophils and neutrophils. Credit: Chamaiporn Naprom/Shutterstock.com
Blood smear sample showing eosinophils and neutrophils. Credit: Chamaiporn Naprom/Shutterstock.com
Five-years of data from over nine thousand fire-fighters who worked at the World Trade Center disaster site were analysed. Accelerated loss of lung function, defined as a reduction in forced expiratory volume in one second (FEV1) of >64 ml/year above expected, was recorded in 13% of the fire-fighters. An improvement in lung function was reported for 8% of the fire-fighters.
Those individuals experiencing a rapid loss of lung function were found to have higher blood concentrations of both eosinophils and neutrophils. There was also a correlation between high eosinophil levels and airflow obstruction. Furthermore, the risk of developing airflow obstruction was four times higher among those fire-fighters who presented with an accelerated decline in lung function compared with those experiencing the expected FEV1 decline.
Review of medical notes from before the disaster revealed that the fire-fighters who had elevated eosinophil and neutrophil levels before attending the World Trade Center disaster were those who experienced accelerated FEV1 decline.
Michael D Weiden, associate professor of medicine and environmental medicine at New York University, commented:
After 9/11, about one in eight firefighters who worked at the World Trade Center had accelerated loss of lung function over the next 15 years. Even in those who had never smoked we found that accelerated loss of lung function increased their risk of airway obstruction and COPD".
Although it may not be possible to extrapolate these findings to other populations, it is hoped that they will motivate further research into the treatment of on-going lung injury.
Sources